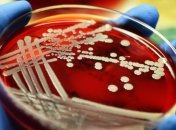
Ученые: Стафилококки "обманывают" антибиотики с помощью "ложных целей"

Новости по теме Стафилококк
-

Неизвестно, успели ли продукция попасть на прилавки украинских супермаркетов
-

Министерства здравоохранения Украины обнародовал первые результаты эпидемиологического расследования случаев заболевания острой кишечной инфекцией.
-

Научные сотрудники восстановили геном сапрофитного стафилококка, который был обнаружен в захоронении на окраине Трои.
-

Накануне в школе в Черновцах в течение короткого промежутка времени заболело несколько десятков учеников, причиной стала инфекция стафилококка.
-
Исследователи объяснили устойчивость золотистого стафилококка к антибиотикам.
-

Во время проверки качества продуктов питания в продуктах для военных центра "Десна" были обнаружены патогенные бактерии стафилококка и кишечной палочки.

